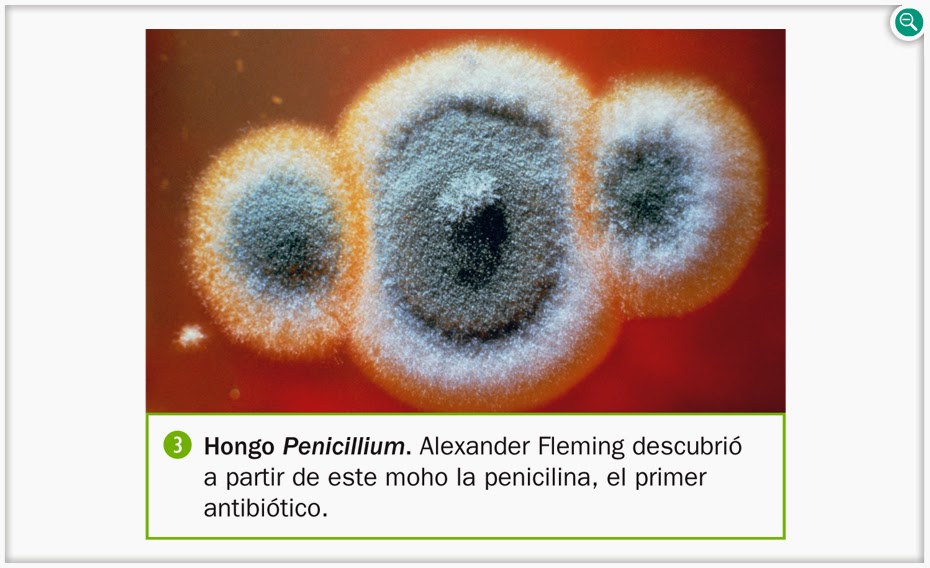

Os dejo unos enlaces para que profundicéis en los contenidos de la unidad. Aprovecharlos para repasar el tema.
Saber más sobre los mitos.
Posesivos.
Actividades con posesivos.
Ejercicio de tíldes en diptongos o hiatos.
Diptongos I.
Diptongos II.
Hiatos.
Hiatos II.
Prefijos y sufijos.
Prefijos y sufijos II.
El teatro I.
El teatro II.
Los textos teatrales.
Ceip Fermín Salvochea

jueves, 30 de octubre de 2014
Unidad 3 de matemáticas: Números enteros.
Aquí os dejo algunos enlaces para que podáis repasar los contenidos del tema 3. Como os he dicho es importante que hagáis muchas actividades.
Números enteros.
Números enteros II.
Números negativos.
Los números y los signos.
Plano cartesiano I.
Plano cartesiano II.
Coordenadas cartesianas.
Coordenadas de un punto del plano.
Busca y localiza.
Números enteros.
Números enteros II.
Números negativos.
Los números y los signos.
Plano cartesiano I.
Plano cartesiano II.
Coordenadas cartesianas.
Coordenadas de un punto del plano.
Busca y localiza.
jueves, 16 de octubre de 2014
Powerpoint del tema 2 de conocimiento.
Aquí os dejo el powerpoint de la unidad 2 de conocimiento. Os servirá para repasar y estudiar el tema.
Unidad 2: La función de nutrición II
Unidad 2: La función de nutrición II
miércoles, 15 de octubre de 2014
jueves, 2 de octubre de 2014
Suscribirse a:
Comentarios (Atom)